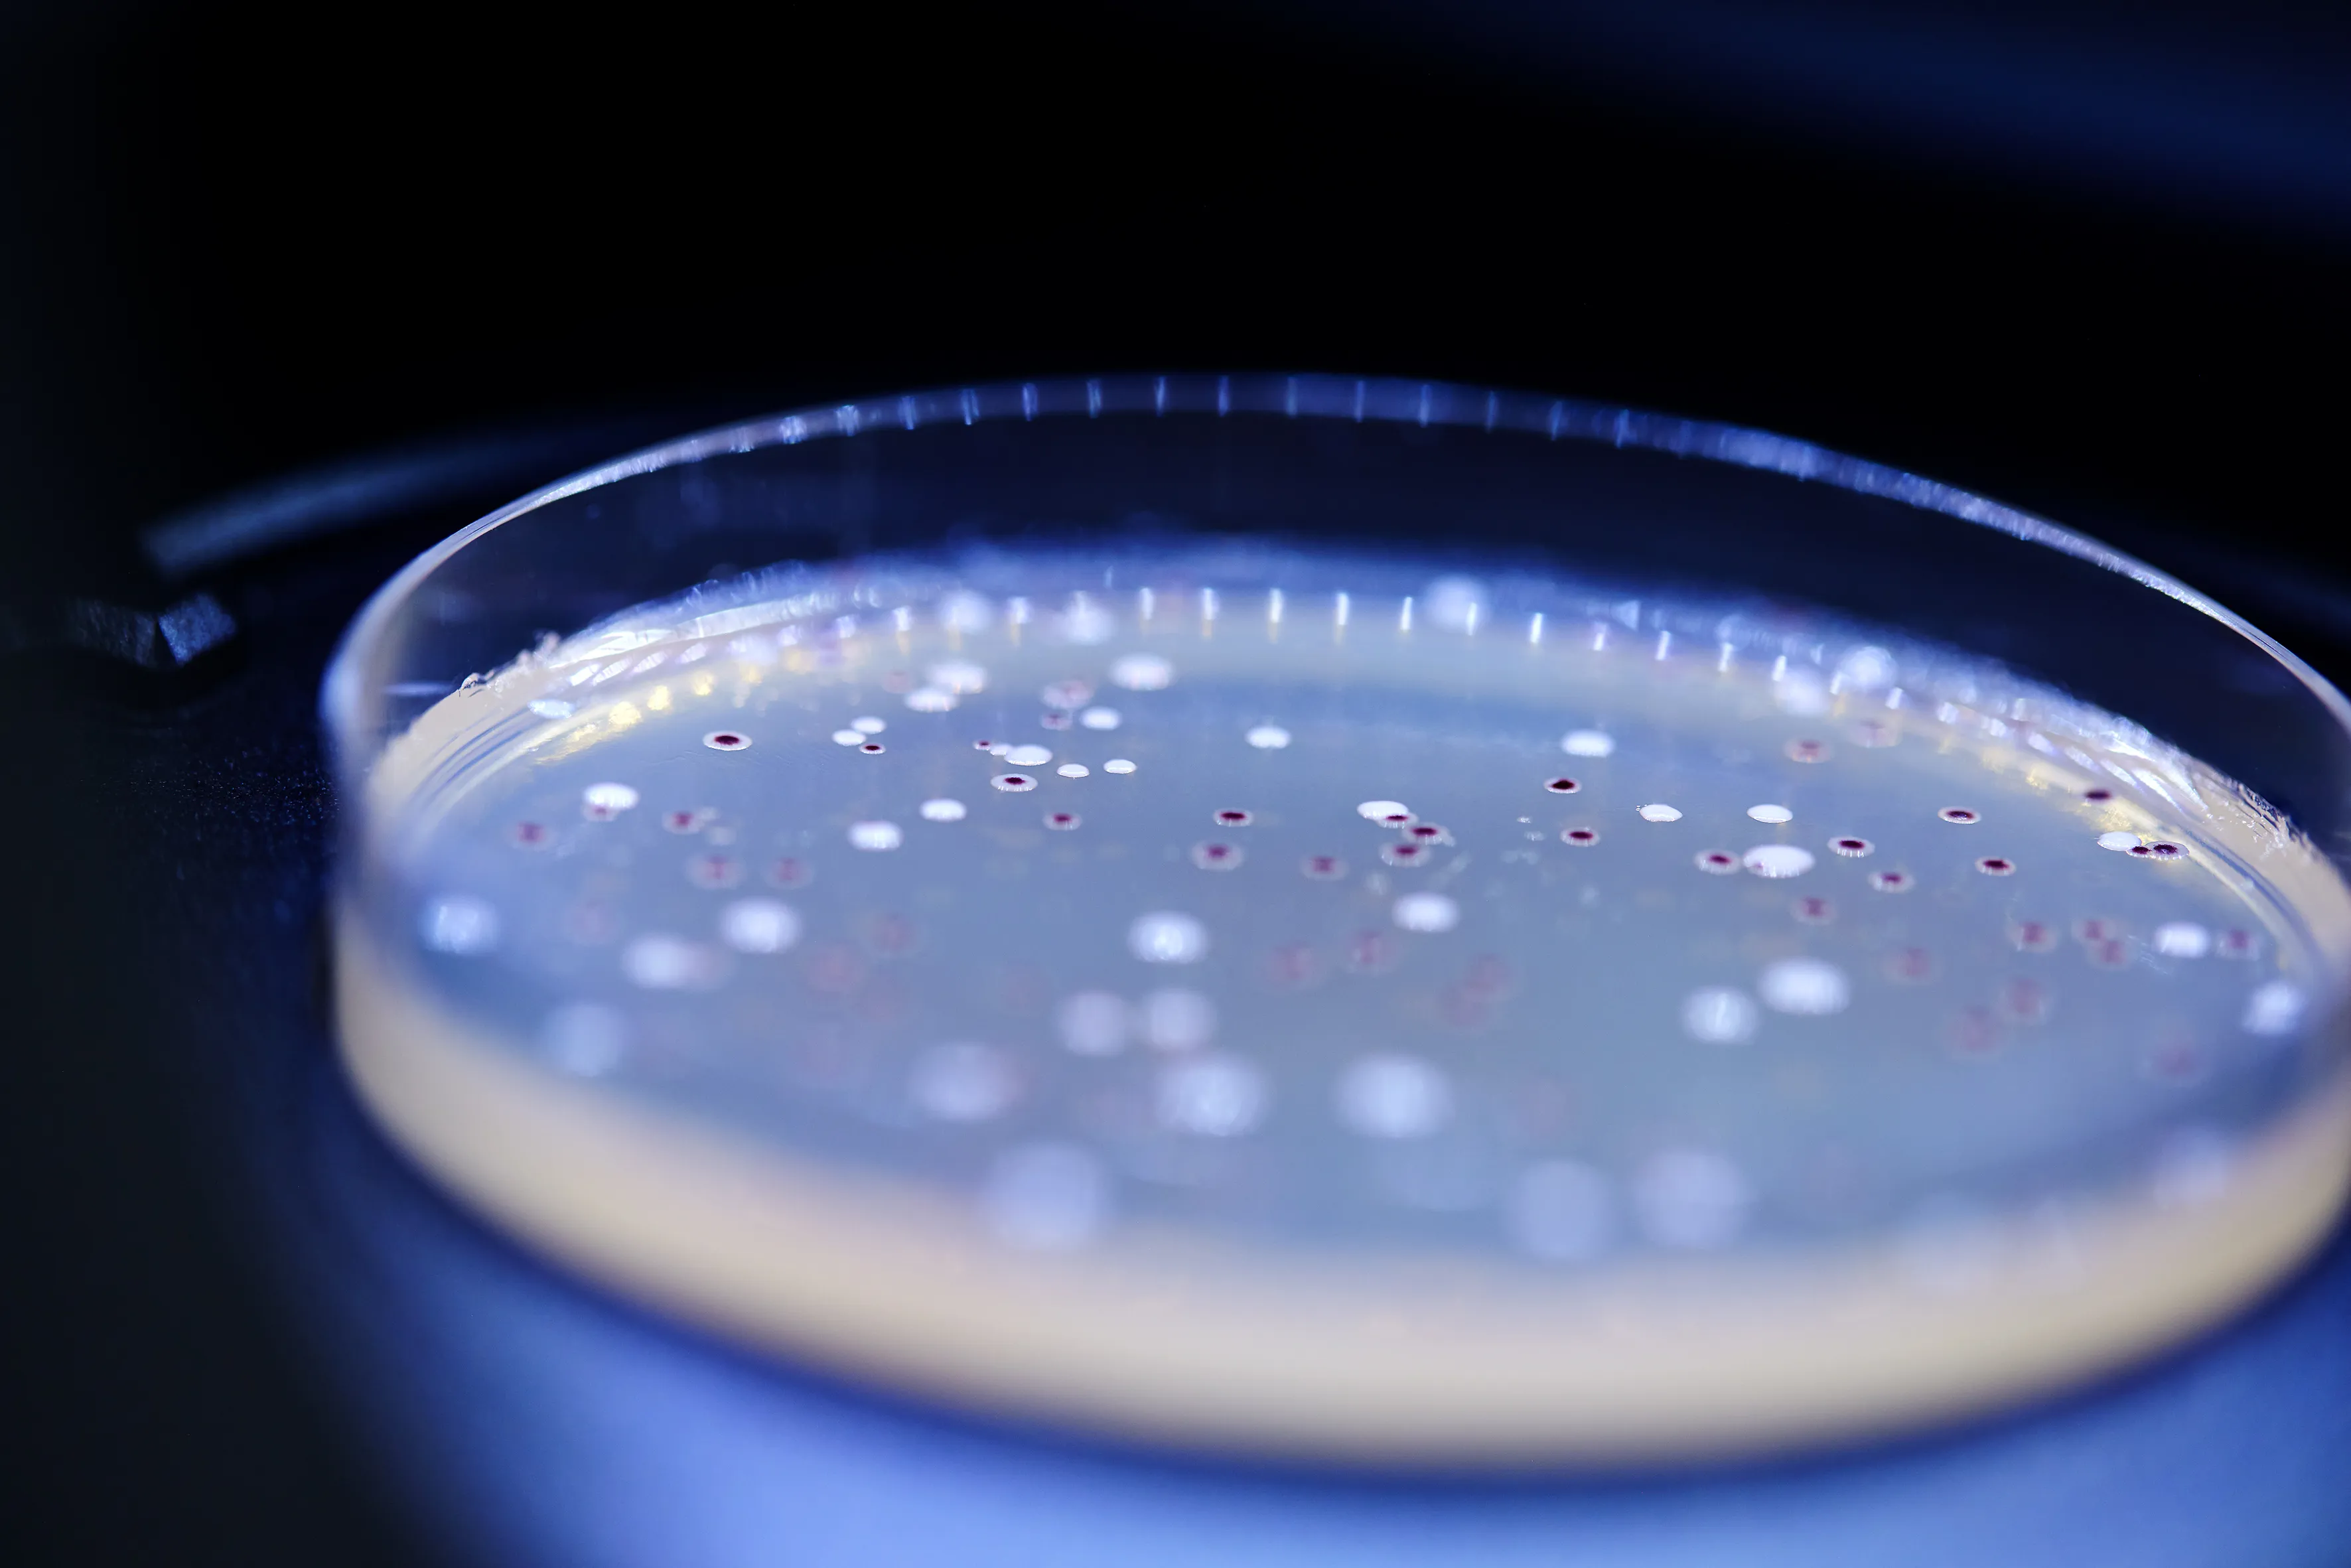
Event

Discover your perfect biotic match
Our product guide helps you quickly match health needs with the best product options. Just a few clicks and you’ll see which solutions fit your innovation plans.
Meet us at Growth Asia Summit July 8-10 in Singapore. Here we look forward to exploring the latest market opportunities that have emerged in Asia.
We will be in Taipei from July 15-19, showcasing the science behind LP299V® for sports performance and HEAL9® for mental health and cognitive support. Visit us in Hall 1, Booth I304, 1F.
Our product guide helps you quickly match health needs with the best product options. Just a few clicks and you’ll see which solutions fit your innovation plans.

With more consumers seeking natural ways to boost energy, endurance, and recovery, the demand for science-backed active nutrition is accelerating. Consumers are looking for multifunctional solutions to help them reach their performance and wellness goals - and the gut plays a central role in this pursuit.

Probi has reinforced its partnership with BLIS Technologies (BLIS®) through an updated agreement, granting Probi exclusive distribution rights for the probiotic strains BLIS K12™ and BLIS M18™ for both human and pet health. This positions Probi at the forefront of oral health innovation.

From single colony to finished products bottled with your own label, our skilled in-house teams can carry you effortlessly through this highly specialized the process.